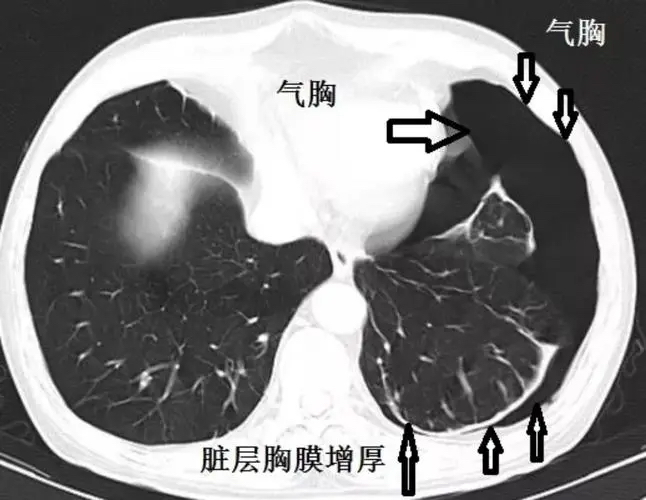

公园对弈需心静,情绪激动引急症
- 发布人:xnxy120
- 时间:2023-09-07
- 来源:
- 浏览量:1155
本网讯(通讯员 许云飘)郴州市的谢叔是一名具有20年烟龄的老烟民,也是一位深度的象棋爱好者,工作之余常常叼着香烟到罗家井附近的小公园找人对弈。三天前,谢叔照例又来到小公园,想看看能否遇到棋友,过一把棋瘾;谁曾想这一溜达,不但象棋没下成,还把自己折腾进了医院。

8月24日,谢叔与棋友因为下棋意见不合,情绪激动地与对方发生了争吵,推搡间谢叔不小心一屁股坐在了地上,当时顿觉左侧胸部传来一阵隐痛,谢叔以为是自己太过生气引发的不适,没多想就回家了。谁知,回家后谢叔的疼痛感越来越明显,同时还感觉到胸闷、气促,家人见此情景,立马将谢叔送至湘南学院附属医院乳甲胸外科就诊。
急诊医师欧阳兵经过仔细问诊体查,并结合谢叔的CT,诊断谢叔是由于外力引发自身肺大泡破裂导致的左边自发性气胸。听此诊断,谢叔很疑惑,自己只是跟别人争吵了几句,摔的那下也没感觉多重,怎么肺就被“气坏”了呢?欧阳兵解释到:“一个正常成人的肺有3.5亿到7亿个肺泡,这些肺泡维持着正常呼吸,如果长期吸烟,或有支气管哮喘等疾病既往史,容易导致肺小泡逐渐融合变成肺大泡;肺大泡在情绪激动、用力咳嗽或受外力撞击的情况下都有可能引发破裂,医学上称之为自发性气胸,多见于高瘦人群和老年人。发病后会突然出现胸痛,严重者会继发胸闷气促、呼吸困难,一旦患者在家出现以上症状,家属应该保持镇静,立即让病人背靠沙发,取半坐卧位,减少活动,立即就医,以免引起不良后果。”
当天下午,欧阳兵为谢叔实施了局麻下行左侧胸腔闭式引流术。此术式的原理为建立一条胸腔与外界的引流通道,把胸腔里积聚的气体或液体引流出来,恢复胸腔内正常的负压状况。治疗后谢叔胸闷气促感明显缓解,疼痛评分也由原来的6分(中度疼痛)降至为2分(轻度疼痛)。
目前,谢叔恢复良好,他感慨自己今后遇事一定要矜平躁释,再不能因为不良情绪,把自己“作”进了医院。
8月24日,谢叔与棋友因为下棋意见不合,情绪激动地与对方发生了争吵,推搡间谢叔不小心一屁股坐在了地上,当时顿觉左侧胸部传来一阵隐痛,谢叔以为是自己太过生气引发的不适,没多想就回家了。谁知,回家后谢叔的疼痛感越来越明显,同时还感觉到胸闷、气促,家人见此情景,立马将谢叔送至湘南学院附属医院乳甲胸外科就诊。
急诊医师欧阳兵经过仔细问诊体查,并结合谢叔的CT,诊断谢叔是由于外力引发自身肺大泡破裂导致的左边自发性气胸。听此诊断,谢叔很疑惑,自己只是跟别人争吵了几句,摔的那下也没感觉多重,怎么肺就被“气坏”了呢?欧阳兵解释到:“一个正常成人的肺有3.5亿到7亿个肺泡,这些肺泡维持着正常呼吸,如果长期吸烟,或有支气管哮喘等疾病既往史,容易导致肺小泡逐渐融合变成肺大泡;肺大泡在情绪激动、用力咳嗽或受外力撞击的情况下都有可能引发破裂,医学上称之为自发性气胸,多见于高瘦人群和老年人。发病后会突然出现胸痛,严重者会继发胸闷气促、呼吸困难,一旦患者在家出现以上症状,家属应该保持镇静,立即让病人背靠沙发,取半坐卧位,减少活动,立即就医,以免引起不良后果。”
当天下午,欧阳兵为谢叔实施了局麻下行左侧胸腔闭式引流术。此术式的原理为建立一条胸腔与外界的引流通道,把胸腔里积聚的气体或液体引流出来,恢复胸腔内正常的负压状况。治疗后谢叔胸闷气促感明显缓解,疼痛评分也由原来的6分(中度疼痛)降至为2分(轻度疼痛)。
目前,谢叔恢复良好,他感慨自己今后遇事一定要矜平躁释,再不能因为不良情绪,把自己“作”进了医院。
编辑:李丽君 审核:李莉 许莉珺


